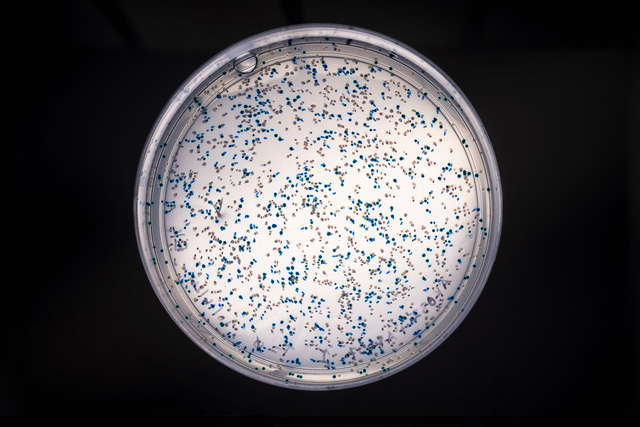

The lab resurrecting ancient proteins to unlock life’s secrets
- Dr. Betül Kaçar is leading a project to resurrect ancient enzymes to reveal insights about life’s origins, the possibility of life throughout the cosmos, and how to adapt to a changing climate.
- Kaçar’s latest project focuses on nitrogenase, the only enzyme that makes nitrogen available to life — a key to both Earth’s past and future.
- Beyond shedding light on how life has adapted to environmental upheavals throughout history, the research could lead to more sustainable farming by helping develop nitrogen-fixing bacteria that reduce reliance on synthetic fertilizers
“I want to change the way we think about the past altogether,” Dr. Betül Kaçar, an astrobiologist who studies the origin of life, told me. “We think of it as some failed state, as if it’s irrelevant. That’s just not true.”
At first, I wasn’t sure what she meant. We analyze history to learn from it — this is not a novel idea. But as we talked, I realized Kaçar wasn’t just arguing for the past’s importance. She was questioning how we frame it. Evolution is often seen as a binary: species either succeed and survive into the present, or they fail and vanish completely. Kaçar challenges that view. To her, the past isn’t just a record of failure and success, but a living force that still shapes how life works today and how we think about what comes next.
This line of thinking — the intersection of science and philosophy — has fueled Kaçar’s work for decades. At the University of Wisconsin, her lab studies the origins of life through enzyme evolution. These proteins, which catalyze biochemical processes, emerged and adapted over billions of years. By resurrecting ancient enzymes and tracing their evolution against environmental shifts, Kaçar and her team aren’t just looking back — they’re uncovering insights that could help us navigate an uncertain future.
Her groundbreaking research has earned her a distinguished reputation. But what struck me most about Kaçar wasn’t just the scale of her research or the boldness of her ideas — it was how she spoke about them. Many scientists focus on mechanisms: chemical reactions, evolutionary trees, molecular pathways. Kaçar does too. But she also elegantly talks about continuity, about life as an interconnected process shaped by time and adaptation. To her, ignoring the past is like ignoring the most impressive dataset in existence: organisms and molecules that have survived more than 3 billion years of change, a span no lab experiment could ever replicate.
It’s this mindset and perspective, combined with scientific rigor, that has led Kaçar to ask what she calls “big, bold, basic questions” — the ones that kept our ancestors staring at the stars, wondering how it all began and whether life exists elsewhere. They’re also the types you need a new field for, so she made one. And some of the country’s most prestigious scientific institutions have noticed.
In January, Kaçar received a $1.3 million grant from the Keck Foundation, known for funding bold, high-risk, high-reward projects that transcend single disciplines. Her home institution, the University of Wisconsin–Madison, offered matching funds, giving her lab the freedom to pursue ideas that don’t fit neatly into existing research categories.
Big, bold, basic questions
Kaçar describes the Keck funding as a rare opportunity to “ask the big questions.” The project, “Past as Prelude: Preparing for an Uncertain Future Shaped by Nitrogen,” focuses on the evolution of nitrogenase — a crucial enzyme in bacteria that converts atmospheric nitrogen into a form that’s biologically available, sustaining life itself.

Kaçar, alongside colleagues from UW-Madison and a professor from Seoul National University, will use a variety of modern methods to reverse-engineer nitrogenase and map its evolution across key moments of environmental upheaval in Earth’s history. The goal is to understand whether and how the enzyme responded to these critical periods.
The implications are vast and interdisciplinary. This research could refine our understanding of the conditions necessary for life, while also addressing urgent challenges — such as how to sustain crop production in a rapidly changing climate.
Why nitrogen?
In biochemistry, carbon is the superstar — it literally puts the “organic” in “organic chemistry.” But when it comes to life, nitrogen is just as essential. It’s a key component of DNA, proteins, chlorophyll (key for photosynthesis), and countless other biological structures.
Yet for all its importance, nitrogen plays really hard to get. It makes up 78% of the atmosphere, but most living organisms can’t use it because it exists as inert nitrogen gas (N₂), held together by one of chemistry’s strongest glues: a triple bond. Breaking it requires immense energy — lightning can do it, but biologically, only one enzyme can: nitrogenase.
Nitrogenase is found in nitrogen-fixing bacteria, named for their ability to break nitrogen’s triple bond and convert N₂ into ammonia (NH₃), a form life can use. In other words, these bacteria “fix” nitrogen into a usable form. Without this process, life as we know it wouldn’t exist.
Kaçar and her team are particularly interested in nitrogenase because of its longevity and resilience. “At least seven or eight different enzymes can fix carbon from the atmosphere,” she explains. “For nitrogen, there’s only nitrogenase, and it evolved around 2.7 billion years ago. That kind of longevity suggests there’s something important about how life solved this problem early on.”
Creating Franken-zymes
For Kaçar and her colleagues, the singularity of nitrogenase raises a fundamental question: Has nitrogenase remained relatively stable because it was an optimal solution from the beginning, or has it subtly evolved in response to environmental pressures?
That’s the driving question behind her Keck Foundation grant, which funds her lab’s efforts to “reverse-engineer” nitrogenase. In simple terms, this means reconstructing ancient versions, and then testing how they functioned in different environmental conditions. By doing this, Kaçar and her team can determine whether and how nitrogenase evolved in response to changes on Earth.
To answer these questions, Kaçar and her team take a creative approach. Using bioinformatics, a field that applies computational tools to analyze genetic data, they compare the DNA and protein sequences of nitrogenase across different species. By tracing its evolutionary history through phylogenetics — which maps relationships between organisms like a family tree — they predict what nitrogenase looked like billions of years ago. Then, in the lab, they synthesize and test these ancient enzymes — essentially bringing molecular fossils back to life.
The next step? Using “molecular scissors,” as Kaçar calls the method, to place these reconstructed enzymes into modern bacteria. Then, they will take the modern bacteria and expose them to simulated ancient environments to see how the enzyme behaves
“Everyone always compares it to Jurassic Park,” Kaçar said with a slight laugh, perhaps fatigued by the very obvious but not entirely accurate analogy. “In a way, it’s like reconstructing a T. rex — except we don’t have a fossilized ‘bone’ to work with. All we have are the chemical imprints life left behind in the geologic record and clues hidden in modern enzymes — not just in their structure, but in how they’ve evolved and relate to one another. There are fingerprints there, and we’re playing Sherlock Holmes to piece them together.”
By placing these reconstructed enzymes within Earth’s geological timeline, Kaçar can test a key question: Did nitrogenase evolve in response to environmental changes, or has it always been a universal solution? The answer to that question will provide insights into nitrogenase itself, but it will also reveal deeper truths about resilience and evolution.
For example, one key event Kaçar is interested in is the Great Oxygenation Event, a period of time around 2.1 to 2.5 billion years ago when Earth’s atmospheric and oceanic oxygen levels increased dramatically. It was a time of massive environmental upheaval — many organisms died, ocean chemistry shifted dramatically, and life had to adapt to an entirely new atmosphere.
But nitrogenase made it through.
“We know nitrogen-fixing bacteria survived this event, but we don’t know whether nitrogenase changed along the way,” Kaçar says. “Did it subtly evolve to function in a different environment, or did life just work around it? That’s what we’re trying to find out.”
The origin of life
By studying how one of Earth’s most ancient and unchanging molecules has endured billions of years of planetary chaos, Kaçar’s work may reveal something deeper about life’s ability to persist — not just on Earth, but anywhere it might exist in the Universe.
This isn’t just theoretical. Beyond investigating the origin of life and how these insights could help us navigate an uncertain future, Kaçar is also working with NASA.
“We look at two main questions,” she explained. “First, what conditions and chemistry are needed to sustain life? And if we find those conditions, should we expect life to respond the same way it did on Earth — or could it take entirely different paths? Another question is: If every necessary condition is met, does life always emerge, or is there something else we’re missing?”
Sometimes, the questions Kaçar is asking are so big, they’re hard to wrap my mind around. The origin of life, life beyond Earth — these ideas stretch our understanding of what’s possible and force us to literally think big. But her work also raises an equally urgent question:
What about life right now?
Unsurprisingly, Kaçar’s research is leading to major breakthroughs that don’t just help us understand the past or speculate about the future. They’re helping us innovate for the very near future.
One practical and immediate implication of her nitrogenase project is its potential to revolutionize sustainable agriculture — ensuring that crops can continue providing the yields we need while dramatically reducing their environmental impact.
In the natural world, plants get most of their nitrogen from bacteria that use nitrogenase — except for the occasional lightning strike that can fix nitrogen naturally. But this system isn’t enough to sustain the crops we need to feed a growing human population. Enter the Haber-Bosch process — a method that combines nitrogen gas (N₂) with hydrogen gas under extreme heat and pressure to create ammonia (NH₃), the foundation of synthetic fertilizers.
The world runs on synthetic nitrogen
Around 1913, the first industrial-scale applications of Haber Bosch began and dramatically increased crop yields. It’s largely responsible for intensifying crop yields to sustain a growing population. But it comes at a cost. The process is highly energy-intensive: It consumes nearly 2% of the world’s energy supply and contributes significantly to greenhouse gas emissions and water pollution. Scientists have long sought an alternative — one that mimics nature’s efficiency without the environmental downsides.
One promising approach? Harnessing bacteria that naturally fix nitrogen.
Some plants already form symbiotic relationships with nitrogen-fixing bacteria, which produce nitrogenase. Legumes, like pea plants, host these bacteria in their roots, and in exchange, the bacteria convert atmospheric nitrogen into a form the plants can use, freeing them from relying on nitrogen already present in the soil. But many other plants, including major crops like corn and rice, don’t form these relationships.
For years, researchers have explored ways to introduce nitrogen-fixing bacteria into crops to reduce reliance on synthetic fertilizers. This work is ongoing, but there is another problem: The environment is changing, and perhaps today’s nitrogenase isn’t the optimal solution for tomorrow’s world. Kaçar’s work may offer a new path forward.
“Ancient Earth is not that far from us,” Kaçar said. “In many ways, studying the past is also looking into Earth’s future.”
She’s referring to the extreme heat, droughts, and heavy rains predicted with climate change — conditions that will challenge global agriculture in the decades to come.
“We are partnering with botanists and chemical engineers to see if we can recreate nitrogenases from ancient Earth environments and introduce them into nitrogen-fixing bacteria. The goal is to pair these microbes with crops so they can be more resilient to climate change while relying less on synthetic fertilizers.”
If successful, this research could offer a double benefit: a more sustainable way to fertilize crops while helping agriculture adapt to a rapidly changing climate. By looking billions of years into the past, Kaçar’s work could help solve one of the most pressing challenges of the future.
Curiosity over fear
Toward the end of our conversation, after I spoke with Dr. Kaçar about the origins of life, life on other planets, the catastrophic climate changes ahead, and even the scientific method, I admitted that these ideas — though ambitious and bold — felt overwhelming. For many people, myself included, even considering them was daunting. Thinking about our planet’s future as a coming catastrophe, a test of survival for all of us, was something I’d learned to push down over the years. Directly confronting it felt terrifying.
The moment I mentioned my fear, she cut me off, excited.
“I want to challenge that fear!” she said, practically giddy with enthusiasm.
I hadn’t heard anyone talk about the future with such excitement in a long time. She caught my attention.
“Humanity — and all living things — we always take leaps forward when we overcome fear. When we look at what’s coming and use our knowledge and curiosity to move through it. We have the tools now to study how organisms, over billions of years, found ways to persist. That’s what we should focus on.”
She paused, then continued, her words spilling out with conviction.
“There are questions we’ve asked for thousands of years, and our great-great-grandchildren will ask them too. Since humans gained consciousness, we’ve tried to understand our place in the Universe — and we always will. But nothing has been more powerful than the tool we created to seek truth: the scientific method. It allows us to systematically prove ourselves wrong, and in doing so, move forward. For the first time, we can tackle these questions in ways our ancestors never could. I want to tell young scientists — or anyone, really — that they shouldn’t be afraid to ask the big, bold questions. Technology will catch up to you.”
I sat there, uncharacteristically speechless, trying to absorb what she had just said. Then, in a very Betül Kaçar way, she turned to the past to make her point even clearer.
“It’s like what Marie Curie said: ‘Nothing in life is to be feared, it is only to be understood. Now is the time to understand more, so that we may fear less.’”